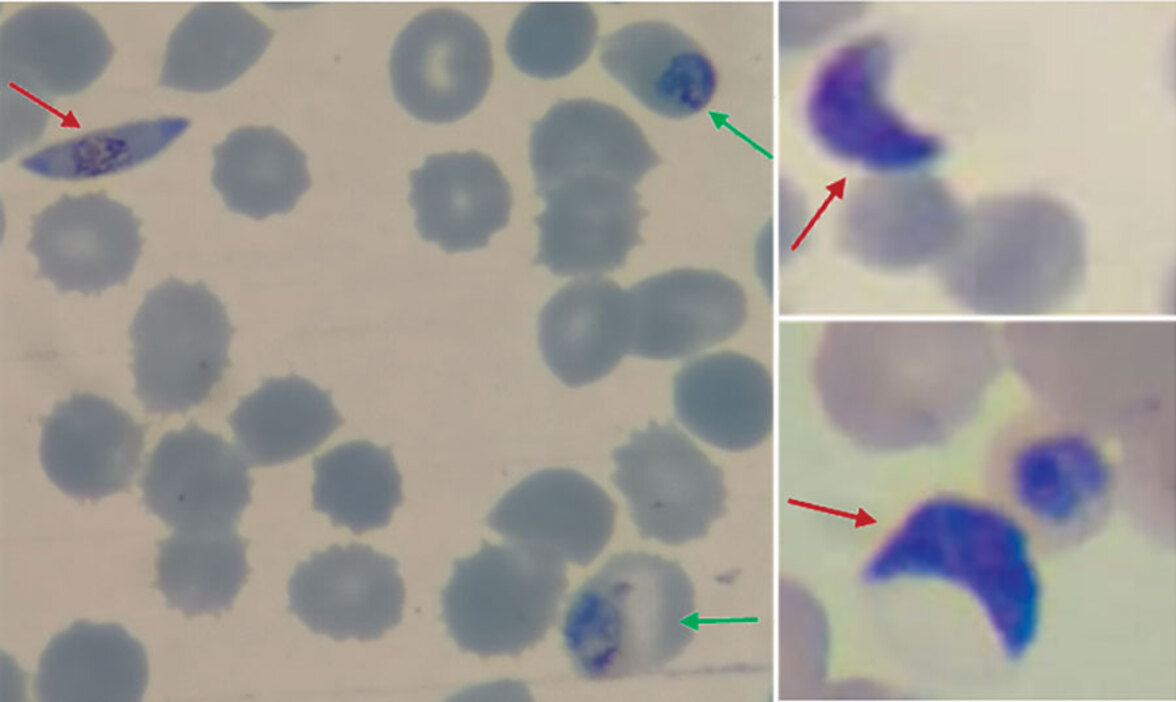
Этимология: Falciparum

От латинского falx или falci (серп или коса) и parum (подобный или равнозначный). Вид falciparum из рода Plasmodium является паразитом, вызывающим малярию у людей.
Для этого паразита было предложено много терминов, таких как Ematozoo falciforme (Antolisei и Angelini в 1890 году) и Haemotozoon falciforme (Thayer и Hewetson в 1895 году), из-за серповидных гаметоцитов. Однако в конечном итоге был принят термин falciparum, предложенный Уильямом Генри Уэлчем в 1897 году.
В 1954 году термин Plasmodium falciparum (ранее Laverania malariae) был одобрен Международной комиссией по зоологической номенклатуре.